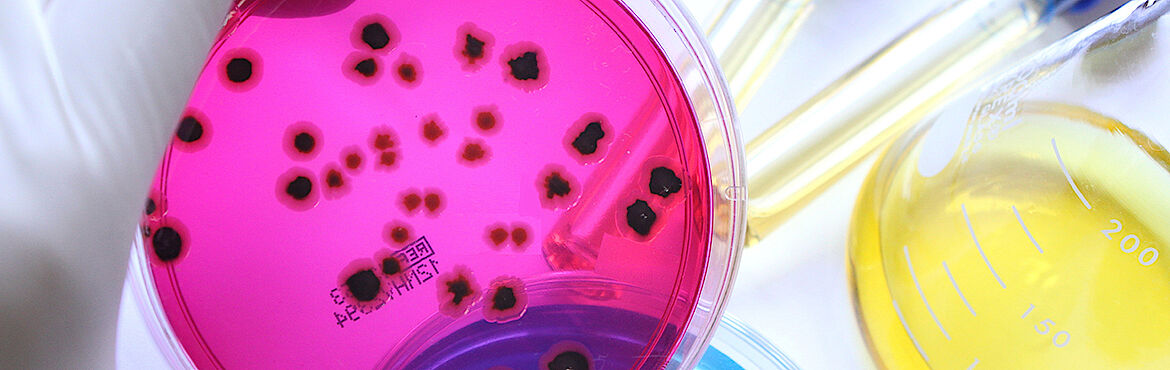
Ausbildung zertifizierte:r Hygienemanager:in & interne:r Auditor:in im Lebensmittelbereich TÜV® Ausbildung zertifizierte:r Hygienemanager:in & interne:r Auditor:in im Lebensmittelbereich TÜV®

Ausbildung zertifizierte:r Hygienemanager:in & interne:r Auditor:in im Lebensmittelbereich TÜV®
Hygienemanagement unterstützt dabei, hohe Qualitätsstandards zu garantieren und gesetzliche Anforderungen zu erfüllen.
Als Hygienemanager:in sind Sie für die Umsetzung der Lebensmittel-Sicherheitsmaßnahmen in Ihrem Betrieb verantwortlich. Als interne:r Auditor:in bekommen Sie wesentliche Einblicke in alle Bereiche Ihres Unternehmens. Durch die Kombination aus dem Bereich Lebensmittelsicherheit und Qualitätsmanagement erhalten Sie außerdem ein optimales Rüstzeug für Ihre internen Audits im Lebensmittelbetrieb. Ebenso werden die Elemente der Schulung im Lebensmittelbereich erarbeitet.
In unserer Komplettausbildung erfahren Sie in 3 Modulen alle Aspekte des Lebensmittelsicherheits- und Hygienemanagements.
Inhalte:
Modul 1: Hygienemanagement, Gute Hygiene Praxis & HACCP
- Gute Hygiene Praxis & Hygienemanagement
- Lebensmittelsicherheit & -mikrobiologie
- HACCP auf Basis des Codex Alimentarius 2022
Modul 2: Lebensmittelrecht, -standards & FCM
- Recht
- Standards & Zertifizierung
- Food Contact Material (FCM)
Modul 3: Food Safety Tools - Schulungen & Audits
- Schulungen
- Audits - Grundlagen und Gesprächsführung
- Audits - Durchführung und Ergebnisse
Die Module können auch als Einzelseminare in beliebiger Reihenfolge besucht werden.
Hygiene- & Qualitätsbeauftragte, Abteilungs- & Teamleiter:innen, Mitglieder der HACCP-Teams aus der LM-Industrie, Gastronomie & Hotellerie, Gemeinschaftsverpflegungen & Caterings, aus dem LM-Groß- & Einzelhandel, Erzeuger von Verpackungsmaterialien
Die Zulassungsvoraussetzungen zur Zertifizierungsprüfung sind: ·
- abgeschlossene Ausbildung Hygienemanager:in der TÜV AUSTRIA Akademie oder eines gleichwertigen Lehrgangs
- Nachweis über eine mind. 1-jährige Berufserfahrung im Bereich Lebensmittelsicherheit/-produktion oder im Qualitätswesen
Die Zertifizierungsprüfung besteht aus einer Projektarbeit inkl. Präsentation beim Fachgespräch und einer schriftlichen Prüfung.
Mit positiver Zertifizierungsprüfung und Erfüllung aller Zulassungsvoraussetzungen erhalten Sie das TÜV AUSTRIA-Zertifikat Hygienemanager:in & interne:r Auditor:in im Lebensmittelbereich, das drei Jahre gültig ist.
Bitte beachten Sie auch das Zertifizierungsprogramm. Dieses und alle weiteren Dokumente zur Zertifizierungsprüfung finden Sie unter Downloads.
Für die Verlängerung Ihres Zertifikates um weitere drei Jahre, ist Folgendes zu übermitteln:
- der Antrag zur Re-Zertifizierung
- Nachweis einer fachspezifischen Weiterbildung im Umfang von mindestens 8 Unterrichtseinheiten (alternativ schriftliche Prüfung)
- Praxisnachweis im Bereich Lebensmittelsicherheit von mind. 2 Jahren (alternativ Fachgespräch)
Der Antrag und die Nachweise können frühestens 6 Monate vor und bis spätestens 6 Monate nach Ablauf des Zertifikates zugesandt werden.
Die passende fachspezifische Weiterbildung zur Aufrechterhaltung Ihres Zertifikats finden Sie hier.
Termine buchen
Zeit:
Modul 1: 11.03.-13.03.2026, 08:30 - 16:30 Uhr
Modul 2: 08.04.-10.04.2026, 08:30 - 16:30 Uhr
Modul 3: 22.04.-24.04.2026, 08:30 - 16:30 Uhr
Termin speichern
Ort: TÜV AUSTRIA AKADEMIE GMBH, campus21 / TÜV AUSTRIA Platz 1, 2345, Brunn am Gebirge
Kurs-Nr.: 26.126.030.01
Teilnahmebetrag: € 4.440,00 zzgl. 20 % USt
Referent:innen: Mag. Dr. Stefan Hackel , Dagmar Leitner, MSc , DI Dr. Ute Stemmer-Letnik
Zeit:
Modul 1: 11.03.-13.03.2026, 08:30 - 16:30 Uhr
Modul 2: 08.04.-10.04.2026, 08:30 - 16:30 Uhr
Modul 3: 22.04.-24.04.2026, 08:30 - 16:30 Uhr
Termin speichern
Ort: TÜV AUSTRIA Online Campus, Online
Kurs-Nr.: 26.126.030.02
Teilnahmebetrag: € 4.440,00 zzgl. 20 % USt
Referent:innen: Mag. Dr. Stefan Hackel , Dagmar Leitner, MSc , DI Dr. Ute Stemmer-Letnik
Zeit:
Modul 1:23.09.-25.09.2026, 08:30 - 16:30 Uhr
Modul 2:14.10.-16.10.2026, 08:30 - 16:30 Uhr
Modul 3:11.11.-13.11.2026, 08:30 - 16:30 Uhr
Termin speichern
Ort: TÜV AUSTRIA Online Campus, Online
Kurs-Nr.: 26.126.030.04
Teilnahmebetrag: € 4.440,00 zzgl. 20 % USt
Referent:innen: Dagmar Leitner, MSc , DI Dr. Ute Stemmer-Letnik , Mag. Dr. Stefan Hackel
Zeit:
Modul 1:23.09.-25.09.2026, 08:30 - 16:30 Uhr
Modul 2:14.10.-16.10.2026, 08:30 - 16:30 Uhr
Modul 3:11.11.-13.11.2026, 08:30 - 16:30 Uhr
Termin speichern
Ort: TÜV AUSTRIA AKADEMIE GMBH, Münchner Bundesstraße 116, 5020, Salzburg
Kurs-Nr.: 26.126.030.03
Teilnahmebetrag: € 4.440,00 zzgl. 20 % USt
Referent:innen: Mag. Dr. Stefan Hackel , Dagmar Leitner, MSc , DI Dr. Ute Stemmer-Letnik
Datum: 30.06.2026 Termin speichern
Zeit: 08:30 - 16:30 Uhr
Ort: TÜV AUSTRIA AKADEMIE GMBH, campus21 / TÜV AUSTRIA Platz 1, 2345, Brunn am Gebirge
Kurs-Nr: 26.226.030.01
Prüfungs- und Zertifikatsgebühr: € 780,00 zzgl. 20 % USt
Prüfung ist über den Kurs buchbar
Datum: 14.12.2026 Termin speichern
Zeit: 08:30 - 16:30 Uhr
Ort: TÜV AUSTRIA Online Campus, Online
Kurs-Nr: 26.226.030.04
Prüfungs- und Zertifikatsgebühr: € 780,00 zzgl. 20 % USt
Prüfung ist über den Kurs buchbar